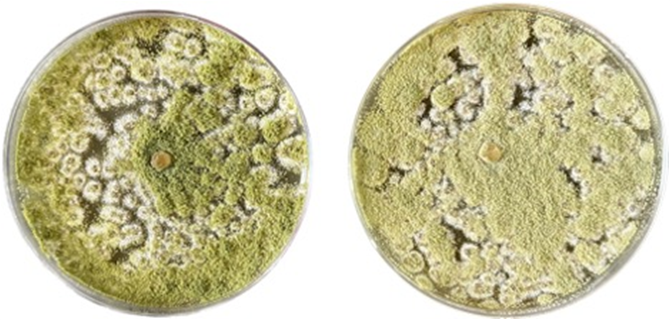
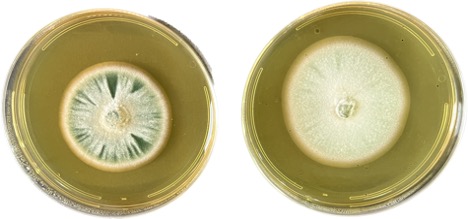
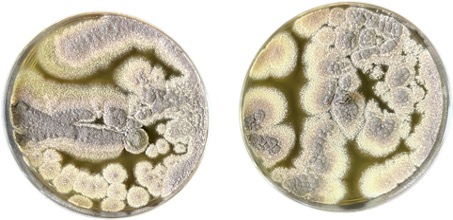
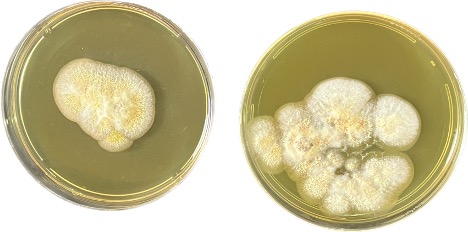

Archive \ Volume.14 2023 Issue 4
Mycotoxins Extracted from Exophytic and Endophytic Fungi Isolated from Catharanthus roseus Plant and Their Toxicity Effect
Shahad Alsubaie1, Fardos Bokhari1, Shahira Hassoubah1, Azhar Najjar1*
1Department of Biological Sciences, Faculty of Sciences, King Abdulaziz University, Jeddah, Saudi Arabia.
Abstract
Secondary metabolites such as mycotoxins can be produced by fungi on agricultural commodities in the field. These fungi can colonize medicinal plants, such as Catharanthus roseus. On the PDA medium, 18 isolates of exophytic and endophytic fungi isolated from C. roseus, including Aspergillus, Penicillium, and Talaromyces species, were tested for mycotoxin production. Thin layer chromatography indicated the formation of six mycotoxins from six isolates, including aflatoxin G1, aflatoxin B1, sterigmatocystin, citrinin, aflatoxin B2, and penicillic acid. To measure the impact of C. roseus leaf extract on the generation of fungal mycotoxin, toxic isolates were cultivated on a PDA medium supplemented with the leaf extract. It was discovered that enriched PDA media could enhance the formation of certain mycotoxins. Toxicity tests were performed on brine shrimp larvae Artemia salina for fungal mycotoxin extraction and C. roseus leaf extraction. Selected fungal extracts at 10 μg/ml were also harmful to brine shrimp larvae, while leaf extracts at 6.25-200 μg/ml were very toxic.
Keywords: Mycotoxins, Catharanthus roseus, Exophytic fungi, Endophytic fungi, TLC
INTRODUCTION
Fungal populations live on the surfaces of plants (exophytic) and within their tissues (endophytic). Long-term evolution has resulted in sophisticated interactions between various species, resulting in a symbiotic connection rather than them continuing as independent entities [1]. Interactions between these microbes and plants are thought to benefit plant survival, biodiversity, and ecosystem function. Most plant species have varied microbial endo- and exophyte populations, as well as non-pathogenic fungi that colonize the inside or surface of plants. Fungi that are exophytic or epiphytic can be found on the surface of living, healthy plant components. The name epiphytes is derived from two Greek words: 'epi,' which means upon, and 'phyton,' which means plant. They vary in size, density, and kind based on biotic and abiotic elements that influence their growth and vitality. Endophytic fungi are organisms that can live in all healthy plant tissues without interfering with their physiological functions. These microorganisms can regulate phytopathogens and herbivorous insects and create growth-promoting chemicals [2].
Secondary metabolites produced by fungi include mycotoxins, antibiotics, and pigments. Mycotoxins are naturally formed on agricultural commodities by filamentous fungi in the field and during storage under a variety of environmental circumstances [3]. Different mycotoxigenic species create a wide range of mycotoxins. Food and feed safety is largely concerned with the harmful mycotoxins generated by certain filamentous fungus fungal genera, such as Aspergillus, Fusarium, and Penicillium, which comprise several species that produce the most mycotoxins globally. These comprise ochratoxins, fumonisins, zearalenones, aflatoxins, and trichothecenes. The most significant mycotoxin that Aspergillus species produce is aflatoxin. It is significant to remember that aflatoxins come in four main forms: B1, B2, G1, and G2. The luminous blue and green colors on thin-layer chromatography (TLC) plates under UV light are the source of the designation "B" and "G." Thus far, hundreds of distinct mycotoxins have been identified, displaying a wide range of structural variations that lead to distinct chemical and physical characteristics [4]. Mycotoxicosis is the name given to the toxic reaction that occurs when mycotoxins are consumed. Mycotoxins have varied degrees of deleterious impact on animal health depending on the type, dose, and duration of ingestion. These compounds can have a wide range of harmful effects on both animals and humans, including cytotoxicity, nephrotoxicity, neurotoxicity, carcinogenesis, mutagenesis, immunosuppression, and estrogenic effects. Climate change, which has a major effect on fungal development, dispersion, and mycotoxin production, may enhance the hazards mycotoxigenic fungi pose to food and feed safety [5]. Fungi seek an environment in which most nutrients may be supplied in considerable quantities to proliferate and create secondary metabolites. Carbohydrates, proteins, and vital fatty acids are examples of these nutrients. While botanicals have a long history and are widely used as foods and traditional remedies, few investigations on molds and mycotoxins contamination have been undertaken, compared to numerous papers on the contamination of grains and oilseeds. Botanicals have been found to have high quantities of Aspergillus, Penicillium, and Fusarium species [6].
Catharanthus roseus is a tropical plant endemic to Madagascar and southern Asia that is classified as a member of the Apocynaceae family. Catharanthus roseus is an important medicinal plant that plays an important part in worldwide health. The medicinal plant C. roseus, according to researchers, has a group of alkaloids that are highly poisonous but have therapeutic potential. Plants were able to perform several biological activities and protect against predators such as insects, fungi, and herbivorous mammals due to their ability to synthesize a diverse range of chemical compounds. Various extracts and isolated compounds of C. roseus have been reported to have anticancer and cytotoxic, antibacterial, antidiabetic, antioxidant, anthelminthic, and larvicidal effects. Carbohydrates, flavonoids, saponins, and alkaloids are found in Catharanthus roseus [7]. The goal of this study was to look at the potential of fungal isolates to produce mycotoxin and their toxicity.
MATERIALS AND METHODS
Two media were employed for fungal mycotoxin generation screening: PDA with 200 dextrose 20, agar15, and 1L distilled water. The second was a PDA medium supplemented with leaf extract containing 250 mL of PDA medium and 400 mg/L of C. roseus leaf extract.
Screening of Mycotoxin Extracted from Fungal Isolates Growing on PDA Medium
Exophytic and endophytic fungi, including Aspergillus, Penicillium, and Talaromyces species, were used to isolate 18 isolates. These selected isolates are capable of producing various mycotoxins. Fungal isolates were cultured in PDA medium for 10 days at 28°C [8]. Agar plugs were removed with a flame-sterilized stainless-steel cork borer (4 mm) at the colony's core. In a screw-capped bijou bottle, the plugs were immersed in 2 ml of chloroform: methanol combination (2:1, v/v). For each extract, 20 ul of the mixture was spotted onto the application line TLC plates with a micropipette and dried with a cool domestic hairdryer. In the solvent system, individual plates containing extract spots were created. The organic layer was collected in amber vials and stored at -20 °C for later investigation.
Effect of Supplemented PDA Medium with Leaf Extract on Toxigenic Isolates
Absolute ethanol was used to make the C. roseus leaf extract. Twenty g of the leaf samples were homogenized with 200 cc of the solvent. The crude preparation was placed in the shaker overnight at room temperature before being centrifuged at 4000 rpm for 20 minutes. After that, the leaf extract-containing supernatant was moved to a beaker that had been previously weighed. The solvent was then evaporated at 60ºC to concentrate the extract. The crude extract was weighed and diluted in a predetermined volume of dimethyl sulfoxide (DMSO) and then refrigerated in a sterile bottle until utilized [9]. To assess the capacity of the fungal isolates to create mycotoxins, a PDA medium supplemented with C. roseus leaf extract was utilized as a supplementary nutritional source. Toxigenic fungal isolates were plated on PDA supplemented with (400 mg/L) C. roseus leaf extract and cultured for 10 days at 28°C. The same approach was then used to record fungal mycotoxins. They were compared to isolates that had been plated on a PDA medium as a control.
Fungal Mycotoxin Extraction
Based on mycotoxin production, six fungal isolates were chosen from exophytic and endophytic fungi, including Aspergillus, Penicillium, and Talaromyces species. Fungal isolates were plated on PDA medium and PDA medium enriched with leaf extract and cultured at 28°C for 10 days [10]. Agar plugs were extracted from each medium plate using a flame-sterilized scalpel and a flame-sterilized stainless-steel cork borer (4 mm) that was used to cut out the plugs close to the colony's center. The plugs were placed in a screw-capped bijou bottle with 2 ccs of chloroform: methanol combination (2:1, v/v). For each extract, 20 l of the mixture was placed onto the application line TLC plates with a micropipette and dried with a domestic hairdryer (cold). In the solvent technique, individual plates dotted with extracts were created. The organic layer was collected in amber bottles and kept at -20 °C for subsequent study.
Detection of Mycotoxin by TLC Protocol
(aluminum-backed, DC-Alufolien-Kieselgel silica gel matrix) was cut to 10 × 10 cm and spotted 1.5 cm from the bottom with 10 l aliquots of extracts or standards for mycotoxin extracts analysis. The plates were developed at room temperature in the solvent solution (toluene, ethyl acetate, and 90% formic acid, T: E: F, 5:4:1 v/v) until the solvent front reached a line indicated 1cm from the plate's top. The plates were taken from the solvent and air-dried in a fume cabinet without any extra chemical reagents after development. The plates are analyzed in a Chromato-Vue cabinet (Model UVP Upland, CA, USA) using UV light at short (254 nm) and long (366 nm) wavelengths, as reported by Samson et al. (2004) [11]. Colored chemicals were studied under visible light, while fluorescent substances were examined under UV light. Sarker et al. (2018) [12] previously detailed the derivation of the retention factor (Rf) value for mycotoxin toxicity.
Toxicity Test
In this part, six fungal mycotoxin extractions and six C. roseus leaf extractions were performed to assess their toxicity on the brine shrimp A. salina.
Brine Shrimp Larvae Bioassay
Five grams of brine shrimp A. salina eggs were hatched in a 300-milliliter Erlenmeyer flask with 100 milliliters of natural seawater for toxicity testing. The eggs were then incubated at 28°C for 24 to 30 hours under gentle aeration on a rotary shaker that ran at 140 revolutions per minute. Following their hatch, the larvae were gathered and kept at room temperature in fresh saltwater. The population density was adjusted so that each petri dish had roughly 20 larvae in 1 ml of solution [13]. For six fungal mycotoxin extractions, concentrations of 2, 6, and 10 μg/ml were utilized. For leaf extract, concentrations of 0.7, 1.5, 3.125, 6.25, 12.5, 25, 50, 100, and 200 μg/ml were used. Additional petri plates were filled with dimethyl sulfoxide (DMSO) and incubated at 28°C as controls. The average number of larval deaths in each concentration was calculated after 6 hours. Harwig and Scott [14] assessed the toxicity of each extract. the following: 0-9% death rate for non-toxic (NT), 10-49% mortality rate for slightly toxic (ST), 50-89% mortality rate for toxic (T), and 90-100% mortality rate for extremely toxic (VT). Furthermore, Fauziah et al. (2022) [15] calculated the lethal concentration (LC50) that killed fifty percent of the larvae. Agha et al. (2022) [16] used the following equation to compute the percentages of deaths:
|
Mortality%= no. of dead larvae no. of larvae introduced × 100 |
(1) |
RESULTS AND DISCUSSION
Screening of Mycotoxins Extracted from Fungal Isolates Growing on PDA Medium
Exophytic isolates A. caespitosus, A. flavus, A. Janus, A. nidulans, A. niger 1, A. niger 2, Aspergillus sp.1, Aspergillus sp.2, Aspergillus sp.3, P. brevicompactum, P. commune, and T. purpurogenus, and endophytic isolates A. caespitosus, A. elegans, Aspergillus sp. 4, A. versicolor, P. chrysogenum and Penicillium sp. 1were grown on PDA medium and tested for mycotoxin productions as shown in Table 1. Four of the twelve exophytic fungal isolates tested positive for mycotoxin production, accounting for 33% of the total. These isolates were A. caespitosus, A. flavus, A. nidulans, and P. commune. TLC plates exposed to UV light revealed that only three Aspergillus species and one Penicillium species developed mycotoxins. Aflatoxin G1 (green fluorescence) was created by A. caespitosus; aflatoxin B1 (blue fluorescence) was produced by A. flavus; sterigmatocystin (light green fluorescence) was produced by A. nidulans; and citrinin (yellow-green fluorescence) was produced by P. commune. Additionally, two of the six endophytic fungal isolates, A. elegans, and P. chrysogenum, showed evidence of producing mycotoxin. TLC plates under UV light revealed that only one species of Aspergillus and Penicillium produces mycotoxins. Aflatoxin B2 (blue fluorescence) was created by A. elegans, while penicillic acid (green fluorescence) was produced by P. chrysogenum. Three-quarters of the endophytic isolates (two out of six) were toxic. Thin-layer chromatography is an analytical method of separation used for qualitative analysis that makes it possible to identify unknown chemicals and see how complicated combinations of analytes react [17]. It is the most popular and successful analytical technique; it is inexpensive but time-consuming. Aflatoxin was discovered in 50% of the samples and was the most common mycotoxin produced by toxigenic isolates from exophytic and endophytic isolates on the PDA medium, totaling six mycotoxin productions. The findings demonstrated that A. caespitosus developed aflatoxin G1 on a PDA medium for exophytic isolates. Contrary to our findings, Rabie et al. (1977) [18] observed that A. caespitosus generated fumitremorgin B on the PDA medium. On PDA medium, A. flavus developed aflatoxin B1, which is consistent with findings reported by and Al-warshan et al. (2023) [19].
Furthermore, in the PDA medium, A. nidulans produced sterigmatocystin, which is consistent with the findings reported by Keller et al. (2000) [20]. Penicillium commune produced citrinin on the PDA medium in our investigation. Lešić et al. (2021) [21], who discovered that P. commune produced cyclopiazonic acid in a PDA medium, disagree with this result. Our research on endophytic isolates revealed that A. elegans generated aflatoxin B2 on the PDA medium. In contrast to our findings, Palumbo et al. (2007) [22] discovered that A. elegans generated ochratoxin A on PDA media. Additionally, P. chrysogenum generated penicillic acid in PDA media; however, citrinin was reported to be synthesized by Devi et al. [23] in PDA medium. Nonetheless, exophytic fungi from various medicinal plants were found to harbor distinct mycotoxins, including aflatoxin, ochratoxin A, and citrinin, as reported by Ahmad et al. (2014) [24]. Prior studies have demonstrated that a wide variety of toxic exophytic organisms frequently infect plants [25]. Herbal medicine was found to have mildew infestations, which led to widespread fungal growth and mycotoxin accumulation, hence compromising the product's quality and effectiveness. When many mycotoxins are combined, their combined negative impacts on agricultural produce and animal health outweigh their individual effects. For instance, ochratoxin A does not have a significant death rate when used alone, but when combined with aflatoxins, it increases their damaging effects. Numerous studies have shown that mycotoxins produced by fungus endophytes deter insects and other grazing animals. By influencing plant communities and having a major impact on the structure of such communities, these fungi can have a dramatic impact on the ecology and evolution of plants [26]. Other research revealed that mycotoxins could be produced by endophytic fungus, as described by Saini et al. (2021) [27]. Rodriguez and colleagues (2009) [28] categorized endophytes into four classes according to their ecological interactions and mode of transmission. Endophytic fungi may produce mycotoxins due to transmission processes. The endophytic isolate of the same species did not discover mycotoxin production in the current investigation, whereas the exophytic isolate A. caespitosus generated aflatoxin G1. These findings corroborate those of Zainudin and Perumal (2015) [29], who discovered that although fungi are members of the same species, their distinct strains differ physiologically from one another. Thus, various fungal strains within the same species may be unable to create mycotoxins. According to Dong et al. (2023) [30], strain-specific variations in the corresponding toxins' production are noticeable, potentially because of their disparate genetic backgrounds and other regulatory factors. According to Zhang et al. (2020) [31], fungal mycotoxin production may be enhanced by mutant genes. Fungal host-selective toxins (HSTs) are poisonous only to the host plants of the fungus that produces the toxin, according to research by Tsuge et al. (2013) [32]. By training a toxin-sensitive plant to be a good host, the producer can enter and colonize host cells thanks to the potential of this process. HST-producing isolates can only directly enter epidermal cells in plants that are susceptible to toxins. Both the germination of conidia and the hyphae's invasion of the host produce fungal HSTs. Nonspecific toxins, however, can harm a wide variety of plants, whether they are hosts of the pathogen that is creating them.
|
Table 1. Screening of mycotoxins extracted from fungal isolates under UV light growing on PDA medium at 28°C for 10 days. |
|||||||
|
SI no. |
Fungal type |
Fungal genus |
Fungal species |
Mycotoxin productions |
Mycotoxin identified fluorescence under UV light |
Other pigmentations |
|
|
1 |
Exo |
Aspergillus |
A. caespitosus |
+ |
Aflatoxin G1 Green |
+ |
|
|
2 |
A. flavus |
+ |
Aflatoxin B1 Blue |
+ |
|||
|
3 |
A. janus |
- |
- |
- |
- |
||
|
4 |
A. nidulans |
+ |
Sterigmatocystin |
Light green |
+ |
||
|
5 |
A. niger 1 |
- |
- |
- |
+ |
||
|
6 |
A. niger 2 |
+ |
|||||
|
7 |
Aspergillus sp.1 |
- |
|||||
|
8 |
Aspergillus sp.2 |
- |
|||||
|
9 |
Aspergillus sp.3 |
+ |
|||||
|
10 |
Penicillium |
P. brevicompactum |
- |
||||
|
11 |
P. commune |
+ |
Citrinin |
Yellow-green |
+ |
||
|
12 |
Talaromyces |
T. purpurogenus |
- |
- |
- |
+ |
|
|
Total count |
12 |
4 |
33% |
||||
|
13 |
Endo |
Aspergillus |
A. caespitosus |
- |
- |
- |
+ |
|
14 |
A. elegans |
+ |
Aflatoxin B2 |
Blue |
+ |
||
|
15 |
Aspergillus sp.4 |
- |
- |
- |
- |
||
|
16 |
A. versicolor |
||||||
|
17 |
Penicillium |
P. chrysogenum |
+ |
Penicillic acid |
Green |
+ |
|
|
18 |
Penicillium sp.1 |
- |
- |
- |
- |
||
|
Total count |
6 |
2 |
33% |
||||
Effect of Supplemented PDA Medium with Leaf Extract on Toxigenic Isolates
Aspergillus caespitosus, A. flavus, A. nidulans, A. elegans, P. commune, and P. chrysogenum were among the exophytic and endophytic toxic fungal isolates that were able to thrive on both control and supplemented PDA media containing C. roseus leaf extract. As seen in Figure 1, the effects of the supplemented PDA medium and the control PDA medium on the growth of various fungi, such as A. flavus, P. commune, and P. chrysogenum, are comparable. As seen in Figure 2, the augmented PDA was able to promote the growth of various fungi, including A. caespitosus, A. nidulans, and A. elegans. Furthermore, Figure 3 illustrates how the addition of leaf extract to the PDA medium enhanced the synthesis of mycotoxin in toxigenic isolates when compared to control PDA media exposed to UV light. Aflatoxin G1 (green fluorescence) and aflatoxin B1 (blue fluorescence) were produced on the control PDA medium by exophytic isolates A. caespitosus and A. flavus, respectively. Verruculogen (greenish-blue fluorescence) and cyclopiazonic acid (red-green fluorescence) were only presented and identified on supplemented PDA medium with C. roseus leaf extract. While the control PDA medium only detected aflatoxin B2 by endophytic isolate A. elegans, the supplemented PDA medium containing C. roseus leaf extract was able to stimulate the production of aflatoxin B2 with blue fluorescence, ochratoxin A with blue-green fluorescence, and sterigmatocystin with light green fluorescence. However, as Figure 4 illustrates, the effects of the supplemented and control media are comparable in identifying the production of sterigmatocystin with light green fluorescence, citrinin yellow-green fluorescence, and penicillic acid with green fluorescence by the exophytic isolates A. nidulans, P. commune, and P. chrysogenum, respectively. In the current study, we found more compounds on TLC plates derived from fungal extracts that were grown on a PDA medium that was supplemented with C. roseus leaf extract. We proposed that plant chemicals induced fungal secondary metabolites to produce additional bands on TLC plates, which could be the consequence of pigments originating from plants. According to Frisvad (2012) [25], plant secondary metabolites stimulate the production of fungal secondary metabolites through epigenetic remodeling. Consequently, adding plant extracts to various media frequently increases the production of fungal secondary metabolites. As was covered in the preceding section, mycotoxin was formed at varying rates when fungal toxigenic isolates were cultivated on a PDA medium that was both controlled and supplemented with leaf extract. Toxigenic isolates on the leaf extract enriched PDA medium developed nine mycotoxins. On supplemented PDA media containing leaf extract, several mycotoxins were induced to be produced by certain toxigenic isolates, such as A. caespitosus, A. flavus, and A. elegans. Our findings for exophytic isolates demonstrated that A. caespitosus produced verruculogen on leaf extract-supplemented PDA medium but not on the control PDA medium. The findings of Schroeder et al. (1975) [33], who claimed that growing verruculogen on cracked field corn required specific nutrient needs to identify the verruculogen, were consistent with this conclusion. Furthermore, on a PDA medium enriched with leaf extract, A. flavus produced both cyclopiazonic acid and aflatoxin B1, whereas only aflatoxin B1 was formed on the control PDA medium. These findings corroborated those of Astoreca et al. (2014) [34] and Bíro et al. (2009) [35], who found that A. flavus produced more aflatoxin B1 and cyclopiazonic acid when the Czapek yeast agar medium (CYA) and corn extract agar medium (CEM) had a high moisture content and were rich in carbohydrates and protein. Our results showed that A. elegans produced aflatoxin B2, ochratoxin A, and sterigmatocystin on supplemented PDA medium with leaf extract, however only aflatoxin B2 was formed on a control PDA medium for endophytic isolates. Furthermore, on yeast extract sucrose medium (YES), A. elegans produced ochratoxin A, according to reports by Batista et al. (2003) [36] and Akbar et al. (2016) [37]. There is no published material that we are aware of that discusses aflatoxin B2 and sterigmatocystin generated by A. elegans. Furthermore, mycotoxin production was higher in PDA medium supplemented with C. roseus leaf extract due to the availability of nutrients such as protein, fats, carbohydrates, and essential elements such as nitrogen, sulfur, phosphorus, potassium, and silicon for supporting fungal growth and secondary metabolite production [38]. Other toxigenic isolates, including A. nidulans (exophytic), P. commune (exophytic), and P. chrysogenum (endophytic), produced the same mycotoxins on both mediums in this experiment. Aspergillus nidulans, P. commune, and P. chrysogenum can all produce mycotoxins on diverse media, including YES, Malt extract agar (MEA), and Sabouraud dextrose agar (SDA) [39, 40]. Although C. roseus leaf extract is toxic, fungal isolates used in this study can consume toxic leaf extract and produce mycotoxins.
|
|
|
a) |
|
|
|
b) |
|
|
|
c) |
|
Figure 1. The control PDA medium (left) and supplemented PDA medium (right) have similar growth for (a) A. flavus, (b) P. commune, and (c) P. chrysogenum at 28°C for 10 days of incubation. |
|
|
|
a) |
|
|
|
b) |
|
|
|
c) |
|
Figure 2. The growth of (a) A. caespitosus (b) A. nidulans and (c) A. elegans were greater on the supplemented PDA medium (right) compared to the control PDA medium (left) at 28°C for 10 days of incubation. |
|
|
|
a) |
|
|
|
b) |
|
|
|
c) |
|
Figure 3. TLC plates were identified (a) aflatoxin G1 on the control PDA medium (left) and verruculogen on the supplemented PDA medium with C. roseus leaf extract (right) from A. caespitosus, (b) aflatoxin B1 on the control PDA medium (left) and aflatoxin B1 and cyclopiazonic acid on supplemented PDA medium with C. roseus leaf extract (right) from A. flavus and (c) aflatoxin B2, ochratoxin A and sterigmatocystin from A. elegans. |
|
|
|
a) |
|
|
|
b) |
|
|
|
c) |
|
Figure 4. TLC plates were identified same mycotoxins extracted from (a) A. nidulans, (b) P. commune, and (c) P. chrysogenum on control PDA medium (left) and supplemented PDA medium with C. roseus leaf extract (right). |
Brine Shrimp Larvae Bioassay
Artemia salina larvae were examined for sensitivity to 6 fungal extracts, including exophytic isolates A. caespitosus, A. flavus, A. nidulans, P. commune, and T. purpurogenus, and endophytic isolates A. caespitosus, A. elegans, and P. chrysogenum. In this investigation, it was discovered that all the larvae shrimp survived in the nontoxic control DMSO. After 6 hours, all fungal isolates died at high rates even at the maximum concentration of 10 μg/ml. Furthermore, at a concentration of 6 μg/ml, these exophytic and endophytic fungal isolates were hazardous. Among all the fungal isolates, the lowest concentration of 2 μg/ml showed the least amount of harmful and the lowest mortality. At 2 μg/ml, the mild toxicity of A. nidulans (exophytic) and A. elegans (endophytic) extracts was 57% and 55%, respectively. The LC50 for all fungal extracts was found to be 2 μg/ml, as reported in Table 2. The larvae of brine shrimp are susceptible to poisonous chemicals, and the brine shrimp lethal test is an excellent method of determining the toxicity of biological poisons.
The approach has the advantages of being simple to use, quick and affordable, and sensitive to a wide range of chemicals. Several researchers [41] have described bioassays for harmful chemical identification employing A. salina larvae. The current study assessed the susceptibility of brine shrimp larvae to six distinct fungal extracts at three different doses (2, 6, and 10 μg/ml). There is a positive link between fungal concentration extracts of 2-10 μg/ml and the death rate of 49-100%, while the LC50 for all fungal extracts was found to be 2 μg/ml. Meyer's toxicity index determined that the extract is poisonous when the LC50 is less than 1000 μg/ml, resulting in the death of the larvae due to the bioactive chemical found in the extract. When the LC50 value exceeds 1000 μg/ml, the extract is non-toxic [42]. As previously stated, mycotoxin production was discovered in exophytic isolates A. caespitosus, A. flavus, A. nidulans, P. commune, and endophytic isolates A. elegans and P. chrysogenum. These findings were substantiated by shrimp larvae sensitivity data, which revealed that the six toxigenic isolates caused a high number of deaths, particularly A. nidulans (exophytic), which was shown to be the most toxigenic to brine shrimp larvae. These findings corresponded with those of Zainudin and Perumal (2015) [29], who discovered that all mycotoxins isolated from the Aspergillus genus were toxic to brine shrimp larvae regardless of concentration.
|
Table 2. Mortality (%) of the brine shrimp larvae after treatment with fungal extracts. |
||||||
|
SI no. |
Fungal type |
Fungal species |
Mortality after 6 h. |
|||
|
Control |
2 μg/ml |
6 μg/ml |
10 μg/ml |
|||
|
1 |
Exo |
A. caespitosus |
0 |
49% |
73% |
98% |
|
2 |
A. flavus |
0 |
51% |
77% |
100% |
|
|
3 |
A. nidulans |
0 |
57% |
77% |
100% |
|
|
4 |
Endo |
P. commune |
0 |
49% |
70% |
100% |
|
7 |
A. elegans |
0 |
55% |
75% |
100% |
|
|
8 |
P. chrysogenum |
0 |
50% |
76% |
98% |
|
|
Toxicity |
NT |
ST |
T |
VT |
||
The brine shrimp A. salina larvae bioassay was also used to determine the toxicity of C. roseus leaf extracts. In this investigation, it was discovered that all the larvae shrimp survived in the nontoxic DMSO control. The doses (0.7, 1.5, and 3.125 μg/ml) demonstrated modest toxicity after 6 h, although the lowest mortality was recorded at the lowest concentration of 0.7 μg/ml. Furthermore, the concentrations (6.25, 12.5, 25, and 50 μg/ml) were hazardous. At the highest doses (100 and 200 μg/ml), substantial rates of mortality-very toxic were recorded. Furthermore, as demonstrated in Table 3, the LC50 was identified at a concentration of 6.25 μg/ml.
|
Table 3. Mortality (%) of the brine shrimp larvae after treatment with C. roseus leaf extracts. |
||
|
Toxicity |
Mortality after 6 h. |
Leaves extracts |
|
NT |
0% |
Control |
|
ST |
8% |
0.7 μg/ ml |
|
25% |
1.5 μg/ml |
|
|
42% |
3.125 μg/ml |
|
|
T |
52% |
6.25 μg/ ml |
|
65% |
12.5 μg/ml |
|
|
72% |
25 μg/ml |
|
|
88% |
50 μg/ml |
|
|
VT |
97% |
100 μg/ml |
|
100% |
200 μg/ml |
|
The brine shrimp lethality assay is a quick, low-cost, and easy bioassay for assessing the bioactivity of plant extracts; the results usually coincide with the plant's cytotoxicity and anticancer capabilities [43]. As we explained in the last section, the toxicity of herbal extracts is generally valued as LC50 values using Meyer's toxicity index. Extracts with LC50 less than 1000 μg/ml are poisonous, while extracts with LC50 greater than 1000 μg/ml are non-toxic [42]. Brine shrimp larvae were examined for sensitivity to C. roseus ethanolic leaf extracts at nine different doses (0.7, 1.5, 3.125, 6.25, 12.5, 25, 50, 100, and 200 μg/ml). The current investigation found a link between leaf extract concentrations ranging from 0.7 to 200 μg/ml and a fatality rate ranging from 8 to 100%. At a concentration of 6.25 μg/ml, the LC50 was determined. Matata et al. (2018) [44] discovered that C. roseus methanol leaf extract had a brine shrimp LC50 of 6.7 μg/ml, which is similar to the current study's finding. Furthermore, Kabubii (2015) [45] discovered that C. roseus hexane leaf extract was the most cytotoxic, with an LC50 value of 159.78 μg/ml, but C. roseus methanol-water leaf extract yielded a brine shrimp LC50 of 3 μg/ml, which contradicted our findings. According to Fernández et al. (2013) [46], the cytotoxic property of C. roseus leaf extract may be attributable to the presence of anticancer chemicals in the leaf, such as vinblastine and vincristine. Depending on their polarity, different solvents extract variable amounts of components in crude plant material that may be hazardous to biological experiments [47].
CONCLUSION
Thin layer chromatography was used to investigate the ability of 18 chosen isolates from exophytic and endophytic fungus, including Aspergillus, Penicillium, and Talaromyces species, to create mycotoxins on PDA. Exophytic isolates were tested for mycotoxin generation by Aspergillus (9 species), Penicillium (2 species), and Talaromyces (1 species). Aspergillus flavus produced aflatoxin B1, which fluoresced blue; A. nidulans created sterigmatocystin, which fluoresced light green; A. caespitosus produced aflatoxin G1, which fluoresced green; and P. commune produced citrinin, which fluoresced yellow-green. Four of the twelve exophytic isolates were toxigenic, accounting for 33% of the exophytic fungus samples. Endophytic isolates were tested for mycotoxin generation by Aspergillus (4 species) and Penicillium (2 species). Aflatoxin B2 was created by A. elegans with blue fluorescence, and penicillic acid was synthesized by P. chrysogenum with green fluorescence. Furthermore, two of the six endophyte isolates were toxic, accounting for 33% of the endophytic fungus samples. To examine the influence of C. roseus leaf extract on fungal mycotoxin generation, toxic isolates were grown on an enriched PDA medium with C. roseus leaf extract and screened by TLC. Some toxicogenic isolates were found to produce the same mycotoxins as PDA, whilst others boosted their activity and produced more than one mycotoxin. On brine shrimp larvae, identified fungal extracts and C. roseus leaf extracts were tested for toxicity. At the greatest concentration, all fungal isolate extracts revealed high rates of mortality. Furthermore, large amounts of leaf extracts were linked to a high rate of mortality. C. roseus has been utilized as an attractive plant in public places despite its toxicity. The presence of this plant may expose you to potentially dangerous compounds including toxigenic exophytic fungus spores.
ACKNOWLEDGMENTS: This project was supported by the Deanship of Scientific Research (DSR) at King Abdulaziz University, Jeddah. The authors, therefore, acknowledge with thanks DSR.
CONFLICT OF INTEREST: None
FINANCIAL SUPPORT: None
ETHICS STATEMENT: None